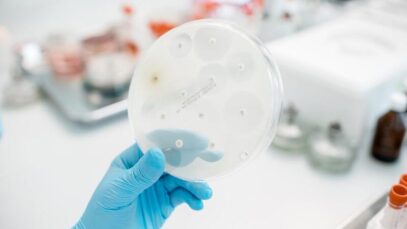
novo antibiótico

![As informações são do g1. O anúncio foi feito em uma coletiva de imprensa com a Agência Nacional de Vigilância Sanitária (Anvisa) e o diretor do Instituto Butantan. Desenvolvida pelo […] Vacina da dengue do Butantan é suspensa após mortes suspeitas](https://panoramafarmaceutico.com.br/wp-content/uploads/2026/06/vacina-dengue-butanta-reproducao-site-691x469.webp)
Vacina da dengue do Butantan é suspensa após mortes suspeitas
As informações são do g1. O anúncio foi feito em uma coletiva de imprensa com a Agência Nacional de Vigilância Sanitária (Anvisa) e o diretor do Instituto Butantan. Desenvolvida pelo […]
Orientações clínicas e as mais recentes descobertas
![As informações são do g1. O anúncio foi feito em uma coletiva de imprensa com a Agência Nacional de Vigilância Sanitária (Anvisa) e o diretor do Instituto Butantan. Desenvolvida pelo […] Vacina da dengue do Butantan é suspensa após mortes suspeitas](https://panoramafarmaceutico.com.br/wp-content/uploads/2026/06/vacina-dengue-butanta-reproducao-site-691x469.webp)
As informações são do g1. O anúncio foi feito em uma coletiva de imprensa com a Agência Nacional de Vigilância Sanitária (Anvisa) e o diretor do Instituto Butantan. Desenvolvida pelo […]




Comece 2024 da melhor maneira possível: com saúde e bem-estar. Realizar um check-up anual é a melhor forma de manter seu corpo saudável e sua mente tranquila. Neste artigo, falaremos […]

A menopausa é um estágio natural na vida das mulheres, mas isso não torna os sintomas associados a ela mais fáceis de suportar, sobretudo quando a transição para esta fase […]

H pylori é uma infecção bacteriana comum que afeta milhões de pessoas em todos os países. Como as pessoas costumam não saber que estão infectadas, é necessário compreender exatamente o […]

Uma insulina inteligente, testada em modelos de camundongos e mini porcos, regulou com sucesso níveis de glicose no sangue por até uma semana e após apenas uma injeção. A descoberta, […]

A Secretária de Saúde do Estado do Acre já confirmou 66 casos de infecções por Oropouche e Mayaro em 10 municípios dos 22 existentes. Os dados são referentes ao último […]
Pesquisadores da Universidade de Harvard e da farmacêutica suíça Roche descobriram um novo antibiótico capaz de matar bactérias multirresistentes a drogas. As informações são da CNN. O artigo com a […]

Os casos de sífilis no Brasil têm aumentado preocupantemente nos últimos anos, diminuindo as taxas de controle que eram mantidas anteriormente. O aumento excessivo de casos tem incomodado o governo, […]

O Brasil bateu recorde de mortes por dengue no ano de 2023. Dados divulgados pelo Ministério da Saúde, por meio do Sistema de Informação de Agravos de Notificação (Sinan online), […]

O município de Umuarama no Paraná iniciou o ano com uma emocionante história, na segunda-feira, 01/01, uma equipe de médicos do Hospital Cemil realizou uma cirurgia de captação de múltiplos […]

Quantos anos viveremos? Será que há alguma maneira de aumentar a nossa longevidade? Essas são algumas das perguntas que muitas pessoas já se fizeram ao longo dos séculos, e que […]





Vagas: 1 Prazo: 25 de junho Inscrição: Clique aqui Taxa de inscrição: R$ 81 a R$ 121 Mais informações: Clique aqui
Vagas: 1 Prazo: 22 de junho, às 23h59 Inscrição: Clique aqui Taxa de inscrição: R$ 80 a R$ 150 Mais informações: Clique aqui
Vagas: 1 Prazo: 14 de junho, às 23h59 Inscrição: Clique aqui Taxa de inscrição: R$ 58,60 a R$ 68,60 Mais informações: Clique aqui
Vagas: 1 Prazo: 12 de junho Inscrição: Clique aqui Taxa de inscrição: R$ 100 a R$ 150 Mais informações: Clique aqui
Conjunto de itens básicos para atendimento imediato em situações de emergência médica até a chegada de assistência profissional
Versão digital oficial da bula de medicamentos, acessível por meio de dispositivos eletrônicos e regulamentada pelas autoridades sanitárias
Fase natural da vida da mulher marcada pela interrupção definitiva dos ciclos menstruais, com implicações hormonais, clínicas e sociais que...
Suplemento que combina diversas vitaminas e minerais em uma única formulação, amplamente utilizado na prevenção de deficiências nutricionais e com...
Receba conteúdos inéditos e novidades gratuitamente
Este site utiliza cookies para melhorar sua navegação, analisar métricas e oferecer recomendações de conteúdo. Você pode ajustar suas preferências a qualquer momento em nossa política de privacidade.